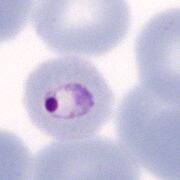
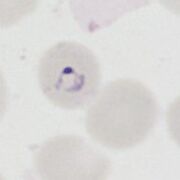
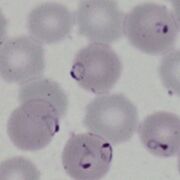
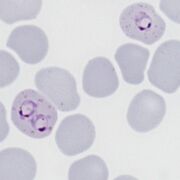
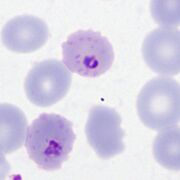
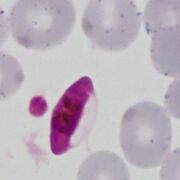

Uploads by Admin
This special page shows all uploaded files.
| Date | Name | Thumbnail | Size | Description | Versions |
|---|---|---|---|---|---|
| 11:57, 11 March 2024 | Ring c.jpg (file) |  |
43 KB | 1 | |
| 12:11, 11 March 2024 | MFETr.jpg (file) |  |
34 KB | 1 | |
| 12:11, 11 March 2024 | MFITr.jpg (file) |  |
34 KB | 1 | |
| 12:12, 11 March 2024 | MFLTr.jpg (file) |  |
60 KB | 1 | |
| 12:25, 11 March 2024 | MOETr.jpg (file) |  |
75 KB | 1 | |
| 12:26, 11 March 2024 | MOITr.jpg (file) |  |
46 KB | 1 | |
| 12:26, 11 March 2024 | MOLTr.jpg (file) |  |
58 KB | 1 | |
| 12:37, 11 March 2024 | MMETr.jpg (file) | |
85 KB | 1 | |
| 12:37, 11 March 2024 | MMITr.jpg (file) |  |
79 KB | 1 | |
| 12:38, 11 March 2024 | MMLTr.jpg (file) |  |
50 KB | 1 | |
| 11:28, 12 March 2024 | MVETr.jpg (file) |  |
48 KB | 1 | |
| 11:28, 12 March 2024 | MVITr.jpg (file) |  |
30 KB | 1 | |
| 11:29, 12 March 2024 | MVLTr.jpg (file) |  |
30 KB | 1 | |
| 11:47, 12 March 2024 | MMLTr2.jpg (file) |  |
25 KB | 1 | |
| 12:18, 12 March 2024 | PFSc.jpg (file) |  |
45 KB | 1 | |
| 17:21, 12 March 2024 | MKETr.jpg (file) | |
28 KB | 1 | |
| 17:22, 12 March 2024 | MKITr.jpg (file) |  |
32 KB | 1 | |
| 17:22, 12 March 2024 | MKLTr.jpg (file) |  |
34 KB | 1 | |
| 19:37, 12 March 2024 | PFET-main image.jpg (file) | |
42 KB | 1 | |
| 15:08, 13 March 2024 | BabRing1.jpg (file) |  |
97 KB | 1 | |
| 15:08, 13 March 2024 | BabRing2.jpg (file) |  |
88 KB | 1 | |
| 15:08, 13 March 2024 | BabRing3.jpg (file) |  |
28 KB | 1 | |
| 16:00, 16 March 2024 | 11multiple1.jpg (file) |  |
30 KB | 1 | |
| 16:00, 16 March 2024 | 11multiple2.jpg (file) |  |
37 KB | 1 | |
| 16:01, 16 March 2024 | 11multiple3.jpg (file) |  |
40 KB | 1 | |
| 16:01, 16 March 2024 | 11multiple4.jpg (file) |  |
40 KB | 1 | |
| 13:11, 19 March 2024 | MFaccole.jpg (file) |  |
50 KB | 1 | |
| 13:11, 19 March 2024 | MMaccole.jpg (file) |  |
64 KB | 1 | |
| 13:11, 19 March 2024 | MVaccole.jpg (file) |  |
60 KB | 1 | |
| 13:12, 19 March 2024 | MOaccole.jpg (file) |  |
42 KB | 1 | |
| 12:04, 20 March 2024 | PFLT-main image.jpg (file) |  |
44 KB | 1 | |
| 12:15, 20 March 2024 | PFG-main image.jpg (file) |  |
35 KB | 1 | |
| 13:32, 20 March 2024 | PFS-main image 2.jpg (file) |  |
37 KB | 1 | |
| 00:18, 21 March 2024 | PFLT1p.jpg (file) | |
50 KB | 1 | |
| 00:19, 21 March 2024 | PFLT2p.jpg (file) |  |
51 KB | 1 | |
| 00:19, 21 March 2024 | PFLT3p.jpg (file) |  |
51 KB | 1 | |
| 00:20, 21 March 2024 | PFLT4p.jpg (file) |  |
49 KB | 1 | |
| 00:20, 21 March 2024 | PFLT5p.jpg (file) | |
58 KB | 1 | |
| 00:40, 21 March 2024 | PFS1p.jpg (file) |  |
27 KB | 1 | |
| 00:40, 21 March 2024 | PFS2p.jpg (file) |  |
56 KB | 1 | |
| 00:40, 21 March 2024 | PFS3p.jpg (file) |  |
43 KB | 1 | |
| 00:41, 21 March 2024 | PFG2.jpg (file) | |
40 KB | 1 | |
| 00:41, 21 March 2024 | PFG3.jpg (file) |  |
31 KB | 1 | |
| 00:41, 21 March 2024 | PFG4.jpg (file) |  |
44 KB | 1 | |
| 18:42, 21 March 2024 | PFSc2.jpg (file) |  |
45 KB | 1 | |
| 18:46, 23 March 2024 | PVETc.jpg (file) |  |
67 KB | 1 | |
| 12:24, 24 March 2024 | PHcorrect.jpg (file) |  |
70 KB | 1 | |
| 12:25, 24 March 2024 | PHincorrect.jpg (file) |  |
83 KB | 1 | |
| 14:01, 24 March 2024 | Maurer1.jpg (file) |  |
57 KB | 1 | |
| 14:01, 24 March 2024 | Maurer2.jpg (file) |  |
50 KB | 1 |